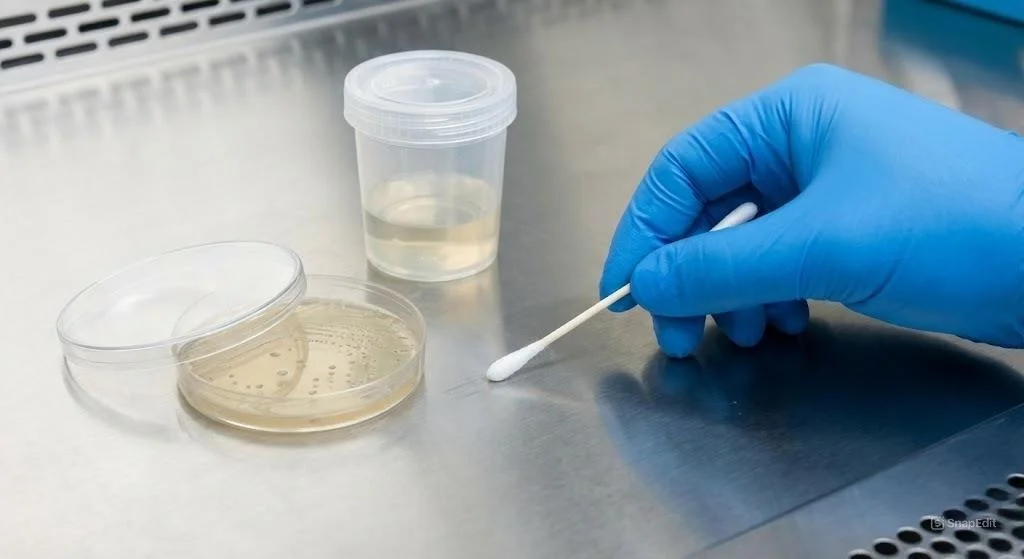
Superficies

En Provalab® desarrollamos un servicio integral para el análisis de compuestos bioactivos y nutricionales como esteroles, vitaminas y ácidos grasos. Nuestro enfoque combina calidad nutricional, inocuidad alimentaria y cumplimiento regulatorio internacional.



Los análisis microbiológicos son estudios de laboratorio que permiten detectar, identificar y cuantificar microorganismos (bacterias y parásitos) presentes en diferentes muestras. Su objetivo principal es evaluar la seguridad, la calidad y la inocuidad de productos y ambientes.

Sirven para comprobar si es apta para consumo humano, riego o recreación, detectando microorganismos patógenos (como E. coli o enterococos) que indican contaminación fecal.

Permiten garantizar que los alimentos no contengan gérmenes que puedan causar intoxicaciones o deterioro, contribuyendo a la seguridad alimentaria y al cumplimiento de normativas sanitarias.
ME-E01 Método para el examen microbiológico de superficies y utensilios.
Los análisis microbiológicos son una herramienta esencial para proteger la salud, asegurar la calidad de productos y preservar el medio ambiente. En PROVALAB cuidamos cada detalle, desde la recepción de la muestra hasta la entrega del resultado, garantizando tiempos de respuesta ágiles y eficientes.